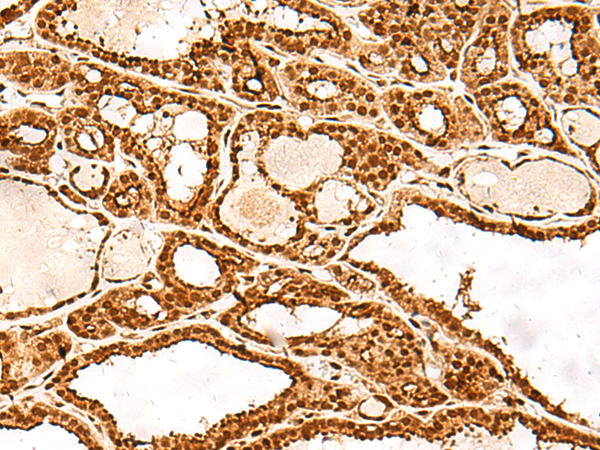

|
Background: |
This gene encodes a member of the adhesion regulating molecule 1 protein family. The encoded protein is a component of the proteasome where it acts as a ubiquitin receptor and recruits the deubiquitinating enzyme, ubiquitin carboxyl-terminal hydrolase L5. Increased levels of the encoded protein are associated with increased cell adhesion, which is likely an indirect effect of this intracellular protein. Dysregulation of this gene has been implicated in carcinogenesis. Alternative splicing results in multiple transcript variants. |
|
Applications: |
ELISA, IHC |
|
Name of antibody: |
ADRM1 |
|
Immunogen: |
Fusion protein of human ADRM1 |
|
Full name: |
adhesion regulating molecule 1 |
|
Synonyms: |
ARM1; ARM-1; GP110 |
|
SwissProt: |
Q16186 |
|
ELISA Recommended dilution: |
5000-10000 |
|
IHC positive control: |
Human tonsil and Human thyroid cancer |
|
IHC Recommend dilution: |
40-200 |

購(gòu)物車
購(gòu)物車 幫助
幫助
 021-54845833/15800441009
021-54845833/15800441009
